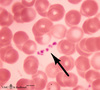

Histology of Blood Cells and Hematopoiesis [LECTURE] | B2 WK4 Flashcards
Blood is a _______ tissue
Connective
What is the composition (%) of blood?
55% Fluid/Plasma
45% Cells
List the functions of blood (3)
- Exchange Medium (Gassess, Nutrients, & Waste Products)
- Carrier of Endocrine Hormones
- Immunity (i.e., contains immune response cells)
What is a hematocrit?
A hematocrit is a means of measuring the volume of red blood cells typically separated by cetrifugation
You have just ran a hematocrit via centrifuge. When looking at the liqud portion (plasma) of the sample, what would you see?
Review: What portion (by volume) is the plasma?
You would see the following breakdown:
- Proteins 7%
- Salts 1%
- Organic Compounds 2%
- Water 90%
7% of plasma contains proteins. What are these proteins?
Albumin
Globulin (Alpha, Beta, Gamma)
Fibrinogen
Albumin is a protein found _____(a)_____ and it functions to _________(b)____________. It is produced by the __________(c)____________.
A: Plasma
B: Maintains pressure in the blood.
C: Liver
alpha, beta, and gamma glubulins are a protein found _____(a)_____ and it functions to _________(b)____________. Gamma is special because it is a ______(c)________.
A: Plasma
B: Diverse carrier and inflammation related proteins
C: Gammas - antibodies
fibrinogen is a protein found in _____(a)_____ and it functions to _________(b)____________.
A: Plasma
B: Key clotting factor
What is a “Buffy Coat”? Where would it be found?
What percentage of a hematocrite-formed elements does it consitute?
Buffy Coat - Leukocytes & Plateletes
1%
What is the “formed element equation”
Hematocrit + Buffy Coat
The total blood volume is ____ plasma.
A. 50%
B. 90%
C. 75%
D. 55%
D :55%
What are the formed elements of blood?
RBC
WBC (Gran/Agran)
Platelets
What tissue is this?

Erythrocyte (Red Blood Cell)
Connective Tissue
What is the composition of Blood (RBC Anatomy essenitally)?
- Plasma Membrane
- Cytoskeleton
- hemoglobin
- lipidsd/ATP
- Carbonic Anhydrase
What is the function of a RBC?
Gas exchange (CO2 & O2 Transport)
How would a RBC appear under a light microscope?
Eosionophilic
Biconcave disk (max. SA for gas exchange)
Center is light

What provides elasticity for passage through capillaries [RBC]?
Cytoskeleton RBS
What proteins would you find in the RBC cytoskeleton? (4 main ones)
- Spectrin
- Actin
- Ankyrin
- Tropomyosin
What is spectrin? Where is it found? What does a mutation cause?
Function: helps maintain biconcave shape of RBC
Found in RBC cytoskeleton
Mutations will yield spherocytosis
What is a band 3 protein-glycophorin do for blood?
It is a extracellular domain of form basis for blood types (ABO)
AKA chain of carbs that give your blood type
Identify the structure
Platelets
What are the functions of platelets?
- coagulate
- form plug
- prevent blood loss
What cell are platelets formed from?
Megakaryocytes (fragmentation)
How long do platelets circulate for?
~8 Days
What are the two regions noted on a slide for platelets?
- Hyalomer (light-stained outer region w/ cytoskeleton)
- Granulomere (darker stained inferior with granules)
Platelets have Granulomeres. What are within Granulomeres? (Seen on a scope)
Lyosomes
Secretory granules (contain ADP, ATP, serotonin growth factors and clotting substrates
What is a granulocyte vs. a agranulocyte
Granulocytes: leukocytes with visible granules in LM with specialized axure-containing dyes (Wright’s or Giesma)
Agranulocytes: cells without prominent granules
List the two types of Neutrophil granulocytes
specific granules
azurophilic granules
What are specific granules?
Specialized functional vesicles (secretory granules/part of phagocytic system) that binds dyes in a distinct manner
What are azurophilic granules?
Lysosomes - present in ALL granulocytes
What WBCs are granulocytes?
-phils are grany
- neutrophil*
- eosinophil*
- basophil*
What WBCs are agranulocytes?
- Monocyte*
- Lymphocyte*
You have conducted a differential White Blood Count on a patient. This patient is healthy and
has normal percentages of the different types of white blood cells. Give the normal or healthy
average for each WBC type.
Monocytes: 2-8%
Neutrophils: 40-75%
Eosinophils: 1-3%
Basophils: >1%
Lymphocytes: ~30% of WBC
STUDY TIP - REMEMBER:
Never Let Monkeys Eat Bananas
What are the functions of neutrophils?
Phagocytes of bacteria, fungi, & viruses
What are the first WBCs on site?
Neutrophils
What is the lifespan of a Neutrophil?
4 days
(hours - 4 days max)
What do neutrophils produce upon death?
Puss
What do neutrophils produce to immobilize bacteria? (i.e., stop the spread the bacteria throughout the body)
NET (Neutrophil extracellular trap)
How do neutrophils move out of the vasculature into CT?
via diapedesis
What is diapedesis?
cells become thin, elongate and move either between or through endothelial cells of capillaries
What are the functions of Eosionophils?
- Defense against parasitic worms
- Effector cells in allergic airway diseases
- Recruited to areas of chronic inflammation (release array of cytokines)
- Phagocytose antigen antibody complexes
What is the lifespand of eosinophils in BLOOD vs in TISSUE
Blood: 6-10 hours
Tissues: 8-12 Days
What are the functions of Basophils?
Defesne against protozoans
Secrete vasoactive agents (histamine, heparin, leukotriene)
Mediate allergic response, hypersensitivity, and anaphylaxis
What WBC has plasma membrane receptors that links antibodies (which antibody?) to antigens to yield a signaling process. This process leads to the degranulation and release of vasoactive agents
Basophil
IgE antibody
What is the lifespan of Basophils?
SHORT
Monocyte functions
phagocytosis
antigen presentation
production of cytokines
What do monocytes mature into in the peropheral tissue?
Monocytes –> macrophages
What is the lifespand for monocytes (what about macrophages?)
Monocytes: Circulation for a few days
Macrophages: years IN TISSUE
What are the specific macrophages for the following locations?
- Brain
- Lung
- Skin
- Lymph Nodes
- Liver
- Synovial Joints
- Brain - Microglia
- Lung - alveolar macrophages
- Skin - langerhan cells
- Lymph Nodes - dendritic cells
- Liver - kupffer cells
- Synovial Joints - lining of synovial membrane
What are the functions of lymphocytes
adaptive & innate immunity
What are the three types of lymphocytes
- B cells
- T Cells
- NK Cells [natural killer]
Is the lifespan of neutrophils LONG or SHORT?
Short
T/F the circulating form of lymphocytes are immunocompetent?
True
Which lymphocyte mediates humoral immunity?
B Lymphocytes
When stimulated by antigens, B-cells proliferate & differentiate into _________________ and produce _________________
Plasma Cells
Antibodies
B Lymphocytes express what three things on their cell surface
- IgM
- IgD
- MHC II
What cells arise from B cells and are highly specialized to produce large amounts of one specifc antibody?
Plasma Cells
This type of lymphocyte comprises 60-80% of lymphocytes - they mediate cellular immunity
T Lymphocytes
What cells recognize antigens bound to MHC II (TH. Treg)
CD4+
What cells recognize antigens bound to MHC I (TC)?
CD8+
[T Killer, cytotoxic T]
This cell comprises 5-10% of lymphocytes
NKC
What do NKC do?
Kill virus-infected cells and some types of tumor cells
T/F: NKC have T cells and their cytotoxicity is not antigen specifc
FALSE
NKC do NOT have T cells, so this means their cytotoxic is NOT antigen specifc
What type of immunity would NKC lymphocytes be grouped as?
Innate
What is hematopoiesis?
Creation of blood cells
Where does hematopoiesis begin in early fetal life?
Blood islands surrounding the yolk sac
At about 2 months hematopoietic centers appear in which organ? What occrus when these centers appear?
Organ: Liver
What happens: Erythropoiesis
At about 3-4 months hematopoiesis ocuurs where?
Spleen and Bone Marrow
AFTER birth hematopoiesis exclusively occurs in the ______________________
Bone Marrow
What are the 2 types of bone marrow?
Red [Hematopoietic]
Yellow [Stromal]
Which bone marrow produces RBC, WBC, and platelets?
Hematopoietic (RED)
Hematopoietic cells mature and migrate into ____________________ to then enter circulation
Sinusoids
What bone marrow produces fat, cartilage, and bone?
Yellow or stromal
How does stromal bone marrow get its color?
Yellow color comes from carotenoids in the fat droplets (in high # of adipocytes)
What is the CT matrix mostly of reticular fibers that supports hematopoietic cords and sinusoids?
Stroma
What is the porgenitor/precursos cells arranged in islands between sinusoids?
Hematopoietic cords
Sinuiods are…
Large diameter capillaries containing erythrocutes and llined by endothelial cells with holes in cytoplasm that permit easy entry of cells
What are multipotent/pluripotent hematopoietic stem cells?
Produce RBC
Myleoid Stem cells form…
- Granulocytes/Monosytes
- Megakaryocytes
- Erythrocytes
Lymphoid stem cells form
- B
- T
- NK
- Other lymphocytes
What are Colony Forming Units (CFUs)?
Progenitor cells that give rise to primarily one cell type
What are the 3 CFUs in myeloid lineage
Erythroid
Thrombocytic
Granulocyte-monocyte
What are considered the precursor cells giving rise to a single lineage?
Blasts
Which cells give rise to multiple differentiated cell types and can proliferate (undergo mitosis) w/o limit BUT division is slow
Stem Cell
Progenitor Cell
Give rise to one or related differentiated cell type
limited proliferation potential
Proliferate MORE than stem cells
Mature Cells
Do not proliferate
Has all morphological characteristics associated w/ function
Precursor/Blast Cells
Very rapid proliferation (a limited # of time)
Some morphological characteristics of the differnetiated cell type, but is not functional
Erythrocytes are derived from the
common myleoid stem cell
What is erythropoietin?
Hormone (glycoprotein) produced by the kidney - stimulates blood cell formation along with growth factors (GM-CSF, IL-3, & IL-4).
During the differentiation process of RBC, what is lost?
Nucleus is extruded
Organelles lost in differentiation process
What is a reticulocyte?
A reticulocyte is a RBC that is released from the bone marrow into circulation
They still contain some ribosomes that can be seen in stains
Within 3 days, the ribosomes are removed and it is offically a mature erythrocyte
What is thrombopiesis? From what cell?
Process of platelet formation from megakaryocytes
Thrombopoiesis is a (___ N) process.
64N - from endomitosis
What are proplatelets?
Long processes that extend into the sinusoids & release platelets directly into circulation
What is endomitosis
DNA replication but NO cell division
Where are the five mature granulocytes found in 5 distinct compartments?
- Granulopoietic region in marrow
- Marrow storage
- Circulating
- Marginating (adhered to endothelium)
- CT (when active)
T/F: Granulopoiesis proliferation and maturation can occur completely out of bone marrow in circulation
F: Can occur completely in bine marrow
(Stimulated by G-CSF, GM-CSF, & IL-3)
Where does full maturation of monocytes occur?
Monocyte –> Macrophage
Occurs in tissue outside of circulation - So they are NOT mature in circulation
Where does the first stage of development in all lymphocytes occur?
Bone marrow
Where does secondary/subsequent development occur?
Primary & Secondary Lymphoid Organs
Lymphocytes in circulation are derviced mainly from the _______________
Thymus
What % of circulating lymphocytes are T cells?
70%
what is the most common cell in circulation?
RBC (Erythrocyte)
Where do mature Eryhtrocytes first appear?
Circulation
Where do mature Platelets first appear?
Bone Marrow
Where do mature Granulocytes first appear?
Bone Marrow
Where do mature Macrophages first appear?
Peripheral Tissue
Where do mature lymphocyte (B Cells) first appear?
Peripheral tissue